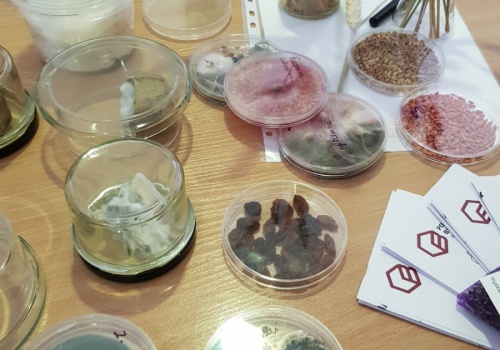

Innowacyjny projekt grantowy dla biologów i informatyków
W roku szkolnym 2023/2024 LMK realizuje projekt edukacyjny finansowany ze środków przyznanych w pilotażowym konkursie grantowym Stowarzyszenia Lokalna Grupa Działania Miasta Włocławka.
Projekt grantowy „Od Programowania obiektowego do bionanotechnologii” umowa nr 1/3/P/2023 realizowany jest w ramach Lokalnej Strategii Rozwoju na lata 2014–2020 Stowarzyszenia LGD Miasto Włocławek, współfinansowany z Europejskiego Funduszu Społecznego w ramach Osi priorytetowej 11. Rozwój Lokalny Kierowany przez Społeczność Działanie 11.1 Włączenie społeczne na obszarach objętych LSR Regionalnego Programu Operacyjnego Województwa Kujawsko-Pomorskiego na lata 2014–2020.
Dofinansowanie projektu wynosi: 50 000,00 zł.

W ramach zajęć uczestnicy projektu mają możliwość brać udział w zajęciach z bionanotechnologii oraz programowania obiektowego prowadzonych przez p. prof. Ilonę Michalską oraz p. prof. Pawła Gmysa, nauczycieli LMK, pomysłodawców inicjatywy. Ponadto zajęcia z neuropsychologii prowadzi p. dr Adam Grudzień, psycholog, pracownik Akademii Mazowieckiej w Płocku.
Dzięki finansowaniu pozyskanemu przez LMK młodzież miała także okazję odbyć wizytę studyjną w laboratoriach Politechniki Bydgoskiej, na Wydziale Rolnictwa i Biotechnologii, gdzie nasi podopieczni zostali przyjęci przez p. Dziekan, prof. dr hab. Annę Wendę-Piesik. Następnie spacerowali po kampusie Wydziału, odwiedzili laboratorium i w ramach Inżynieraliów spotkali się z przedstawicielami przedsiębiorstw współpracujących z Wydziałem oraz ze studentami działającymi w kołach naukowych.
Gratulujemy twórczego działania rozwijającego pasje i talenty naszej młodzieży, które otwiera drzwi nie tylko do świetnych wyników na maturze, ale i sukcesu w późniejszej edukacji oraz na rynku pracy.
Bieżąca inicjatywa stanowi już trzecią z kolei formę współpracy naszej Szkoły ze Stowarzyszeniem Lokalna Grupa Działania. Dwa wcześniejsze projekty to: Piwnica Literacka „U Konopnickiej” oraz Młodzieżowy Klub Filmowca.